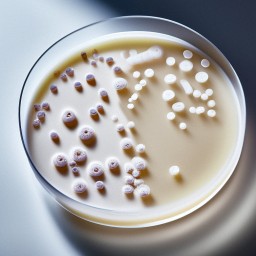
Оценка эффективности нового набора реагентов для выявления мутаций

18.02.2026
Торгово-промышленная палата Российской Федерации
18.02.2026
Торгово-промышленная палата Российской Федерации
 21.03.2025
Зарегистрирован новый набор реагентов «АмплиТест® МБТ-Резист-II»
21.03.2025
Зарегистрирован новый набор реагентов «АмплиТест® МБТ-Резист-II»
Зарегистрирован набор для выявления мутаций, связанных с лекарственной устойчивостью микобактерий туберкулёза к фторхинолонам, методом полимеразной цепной реакции «АмплиТест® МБТ-Резист-II» (ссылка на страницу набора в каталоге).
РУ № РЗН 2025/25001 от 12.03.2025.
 26.02.2025
Зарегистрирован новый набор реагентов «АмплиТест® A Н5/Н7/Н9/H10»
26.02.2025
Зарегистрирован новый набор реагентов «АмплиТест® A Н5/Н7/Н9/H10»
Зарегистрирован набор для выявления и дифференциации РНК вируса гриппа А субтипов Н5, Н7, Н9, H10 методом полимеразной цепной реакции «АмплиТест® A Н5/Н7/Н9/H10»
 25.02.2025
Зарегистрирован новый набор реагентов «АмплиТест® Нейровирусы»
25.02.2025
Зарегистрирован новый набор реагентов «АмплиТест® Нейровирусы»
Зарегистрирован набор для выявления РНК энтеровирусов и парэховирусов человека методом полимеразной цепной реакции «АмплиТест® Нейровирусы»
 17.10.2024
Зарегистрирован новый набор реагентов «АмплиТест® ИМП»
17.10.2024
Зарегистрирован новый набор реагентов «АмплиТест® ИМП»
 03.10.2024
Руководитель ФМБА России Вероника Скворцова вошла в состав Совета Безопасности Российской Федерации
03.10.2024
Руководитель ФМБА России Вероника Скворцова вошла в состав Совета Безопасности Российской Федерации
 09.09.2024
Исследователи из ФГБУ «ЦСП» ФМБА России сообщают о разработке эффективного препарата для лечения ВИЧ-инфекции.
09.09.2024
Исследователи из ФГБУ «ЦСП» ФМБА России сообщают о разработке эффективного препарата для лечения ВИЧ-инфекции.
 05.09.2024
В статье из журнала «Справочник заведующего КДЛ»...
05.09.2024
В статье из журнала «Справочник заведующего КДЛ»...
 22.09.2023
21 сентября состоялся обучающий семинар по продукции АмплиТест
22.09.2023
21 сентября состоялся обучающий семинар по продукции АмплиТест
 Молекулярная диагностика 2023
Молекулярная диагностика 2023
С 14 по 16 ноября 2023 года в Москве (Проспект Мира, д.150, ГК «Космос») состоится XI Международная научно-практическая конференция «Молекулярная диагностика 2023».
Конференция по праву считается ключевым событием в сфере молекулярной диагностики, применения молекулярно-генетических методов в различных областях современного научного знания: от инфекции и онкогенетики до древней ДНК и геронтологии. За 20 лет существования конференция стала уникальной площадкой, объединяющей ведущих мировых ученых. Каждый съезд собирает более 3000 участников из 20 различных стран, принимающих участие в 30 различных секциях и симпозиумах.
В 2023 году запланирована насыщенная трехдневная программа, которая привлечет на мероприятие большое количество активных компетентных делегатов из России и зарубежных стран.
С более подробной информацией можно ознакомиться на сайте.
 Современные подходы и перспективы развития лабораторной диагностики кори
Современные подходы и перспективы развития лабораторной диагностики кори
Оценка эффективности нового набора реагентов для выявления мутаций
Оценка эффективности нового набора реагентов для выявления мутаций
 Design of a Protocol for Soil-Transmitted Helminths (in Light of the Nematode Toxocara canis)
Design of a Protocol for Soil-Transmitted Helminths (in Light of the Nematode Toxocara canis)
 Development and application of an RT‒PCR assay for the identification of the delta and omicron variants of SARS-COV-2
Development and application of an RT‒PCR assay for the identification of the delta and omicron variants of SARS-COV-2
 Genomic epidemiology of SARS-CoV-2 in Russia reveals recurring cross-border transmission throughout 2020
Genomic epidemiology of SARS-CoV-2 in Russia reveals recurring cross-border transmission throughout 2020
 Genomic analysis of the international high-risk clonal lineage Klebsiella pneumoniae sequence type 395
Genomic analysis of the international high-risk clonal lineage Klebsiella pneumoniae sequence type 395
 Genomic Variability of SARS-CoV-2 Omicron Variant Circulating in the Russian Federation
Genomic Variability of SARS-CoV-2 Omicron Variant Circulating in the Russian Federation
 Molecular epidemiology of mcr-1-positive clinical Enterobacterales isolates
Molecular epidemiology of mcr-1-positive clinical Enterobacterales isolates
 Diversities in the gut microbial patterns in patients with atherosclerotic cardiovascular diseases and certain heart failure phenotypes
Diversities in the gut microbial patterns in patients with atherosclerotic cardiovascular diseases and certain heart failure phenotypes
 Модель ВИЧ-инфекции на основе гуманизированных мышей
Модель ВИЧ-инфекции на основе гуманизированных мышей
 Development of Modified Vaccinia Virus Ankara-Based Vaccines: Advantages and Applications
Development of Modified Vaccinia Virus Ankara-Based Vaccines: Advantages and Applications
 Double and Triple Combinations of Broadly Neutralizing Antibodies Provide Efficient Neutralization of All HIV-1 Strains from the Global Panel
Double and Triple Combinations of Broadly Neutralizing Antibodies Provide Efficient Neutralization of All HIV-1 Strains from the Global Panel
 Development and application of LAMP assays for the detection of enteric adenoviruses in feces.
Development and application of LAMP assays for the detection of enteric adenoviruses in feces.
 Complete Genome Sequence, Molecular Characterization and Phylogenetic Relationships of a Temminck’s Stint
Complete Genome Sequence, Molecular Characterization and Phylogenetic Relationships of a Temminck’s Stint
 Сравнительная характеристика кишечной микробиоты у пациентов с хронической сердечной недостаточностью
Сравнительная характеристика кишечной микробиоты у пациентов с хронической сердечной недостаточностью
 Сравнительная характеристика кишечного микробиома у пациентов с неалкогольной жировой болезнью печени и здоровых добровольцев
Сравнительная характеристика кишечного микробиома у пациентов с неалкогольной жировой болезнью печени и здоровых добровольцев
 Molecular-genetic profiling in patients with adenom atous polyps of the gastrointestinal tract
Molecular-genetic profiling in patients with adenom atous polyps of the gastrointestinal tract
 Immunogenic epitope prediction to create a universal influenza vaccine
Immunogenic epitope prediction to create a universal influenza vaccine
 Оптимизация пробоподготовки фекального материала для анализа микробиома
Оптимизация пробоподготовки фекального материала для анализа микробиома

ФГБУ «ЦСП» ФМБА России — это активно развивающийся государственный научный центр, одним из важных направлений деятельности которого является разработка и производство наборов реагентов для диагностики генетических и инфекционных заболеваний.
Контроль на каждом этапе производства даёт возможность выпускать качественную и конкурентоспособную продукцию под маркой «АмплиТест®» и максимально удовлетворять требования и ожидания потребителей.
Все процессы производственной деятельности, а также процессы проектирования и разработки научных инноваций проводятся в соответствии с требованиями международного стандарта ISO 13485 «Medical devices — Quality management systems — Requirements for regulatory purposes» и национального стандарта ГОСТ ISO 13485–2017 «Изделия медицинские. Системы менеджмента качества. Требования для целей регулирования».















Состоялась международная научно-практическая конференция «Молекулярная диагностика 2023», которая собрала рекордное количество гостей из всех регионов Российской Федерации и зарубежных стран. Трехдневная программа конференции включала в себя два пленарных заседания, 35 секций, а также круглый стол по неинвазивному пренатальному тестированию. Организатор мероприятия – ФГБУ «ЦСП» ФМБА России.

Получены регистрационные удостоверения РЗН на наборы реагентов «АмплиТест® СoV-Ag-Express», «АмплиТест® СoV-Inf A/B-Ag», серия 2301, «АмплиТест® МБТ», «АмплиТест® БЛРС CTX-M LAMP», «АмплиТест® CP NDM/ OXA-48/ KPC LAMP», «АмплиТест® CP NDM/ OXA-48/ KPC LAMP Bacto», «АмплиТест® Детские вирусы».

Получены регистрационные удостоверения РЗН на наборы реагентов «АмплиТест® МБТ-LAMP», «АмплиТест® Sepsis-ИХА», «АмплиТест® МБТ-Резист-I Lyo», «АмплиТест® ОКИ LAMP».

Получено положительное заключение РЗН по результатам первичного инспектирования производства ФГБУ «ЦСП» ФМБА России на группу «Медицинские изделия для диагностики in vitro». Было установлено соответствие системы управления качеством медицинских изделий производства установленным требованиям. Результаты опубликованы в реестре Росздравнадзора.

Получены регистрационные удостоверения РЗН на наборы реагентов «АмплиТест® Influenza A Н5/Н7/Н9/H10», «АмплиТест® Нейровирусы», «АмплиТест® МБТ-Резист-II»
